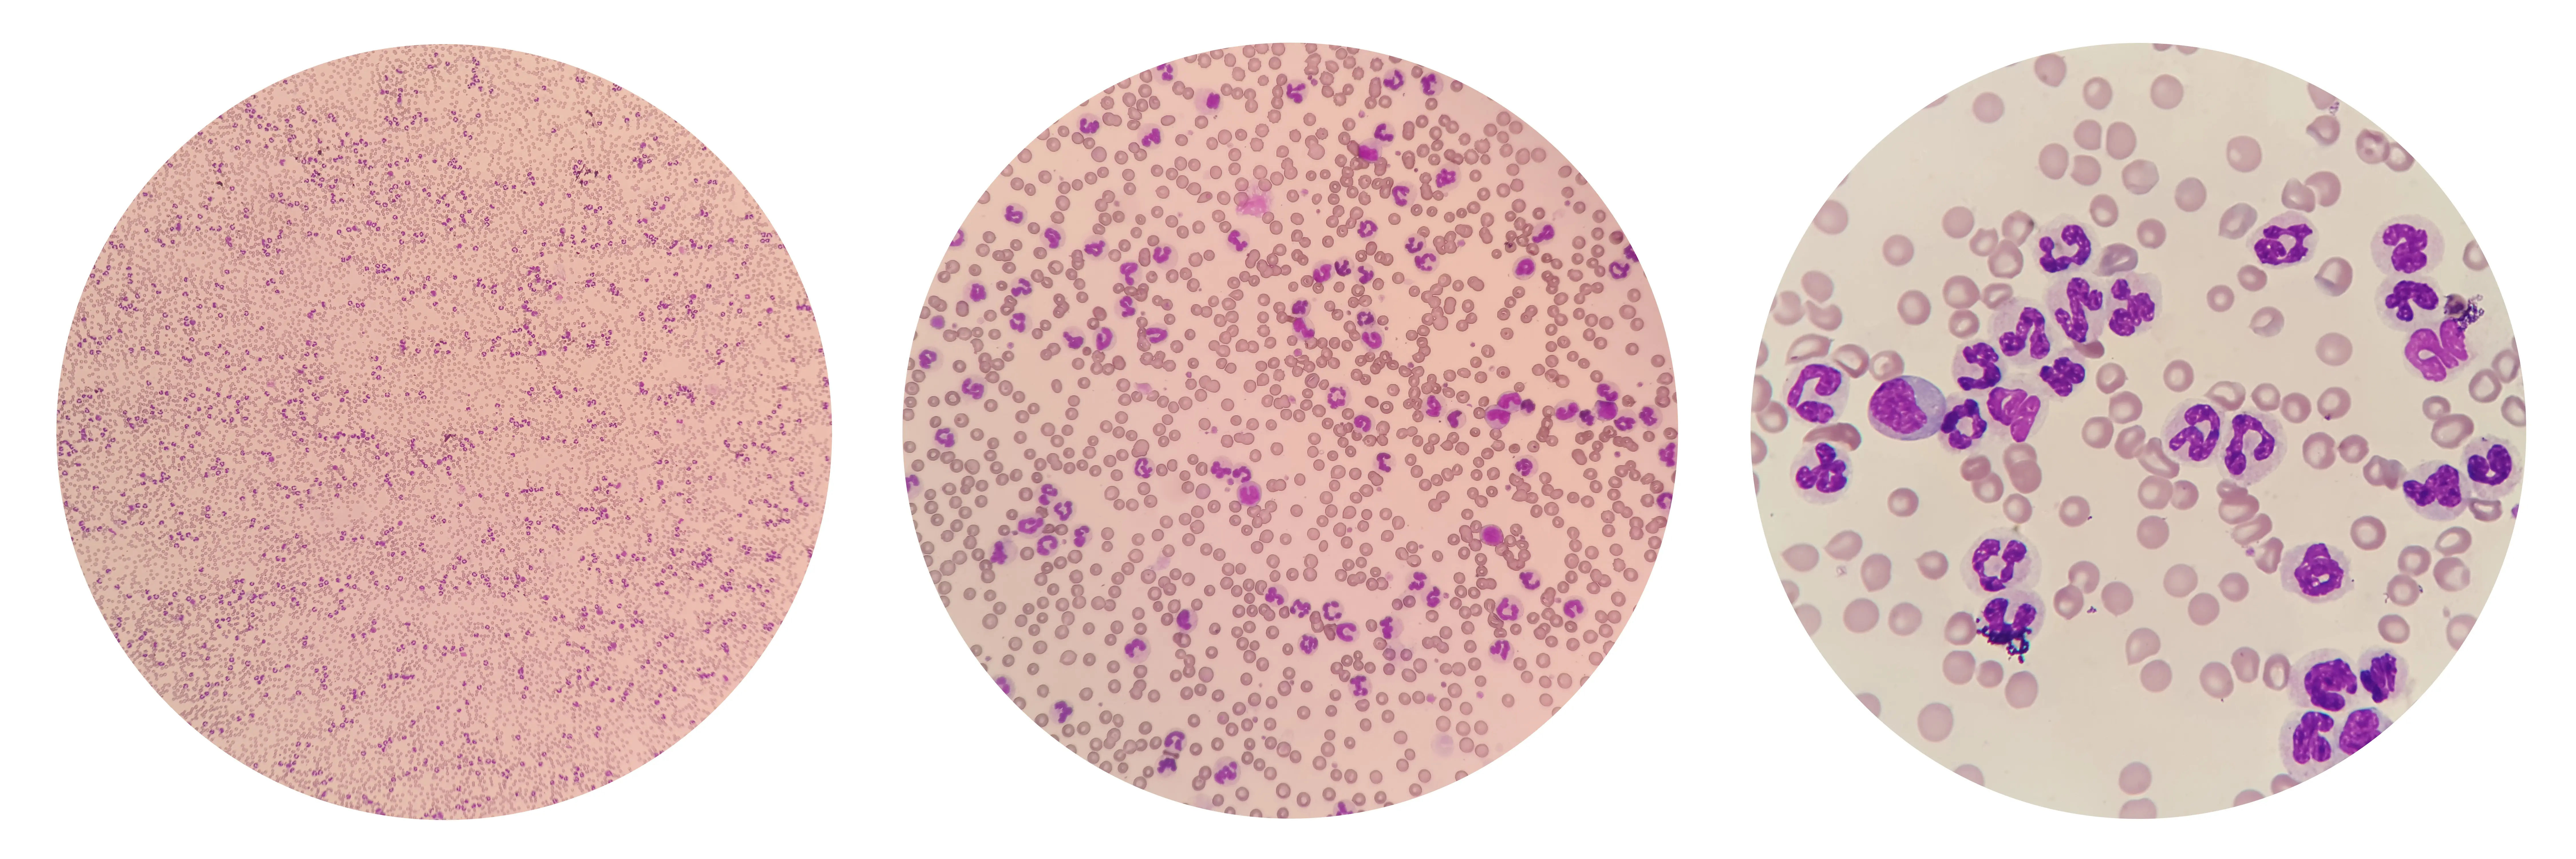

Guide to Dengue Haemorrhagic Fever
Get the essential guide to Dengue Haemorrhagic Fever (DHF). Learn about symptoms, early detection, treatment options, and crucial prevention methods to stay safe.

Written by Dr. J T Hema Pratima
Reviewed by Dr. Rohinipriyanka Pondugula MBBS
Last updated on 13th Jan, 2026

Introduction
Dengue haemorrhagic fever is the dangerous, potentially life-threatening form of dengue—a mosquito-borne viral illness that causes high fever, severe aches, and, in some cases, bleeding and shock. Outbreaks are surging globally, and many families are asking the same questions: How do I recognize the warning signs? What tests confirm dengue? When do I go to the hospital? This guide explains dengue haemorrhagic fever in plain language, so you can act early and confidently. You’ll learn how dengue spreads, the three phases of illness, which symptoms matter most, and exactly when to seek care. We’ll also cover tests like the NS1 antigen and IgM/IgG, the role of fluids and careful monitoring, and why platelet transfusions are not routinely needed. Finally, we’ll show you how to prevent mosquito bites, reduce breeding sites at home, and understand the latest on dengue vaccines. If at any point your fever worsens or you notice warning signs, don’t wait—seek medical advice promptly.
What Is a Dengue Haemorrhagic Fever?
Dengue is caused by any of four related viruses (DENV-1 to DENV-4) spread primarily by Aedes aegypti mosquitoes. Most infections are mild to moderate (often called “dengue fever”), but a minority progress to severe dengue, historically called dengue haemorrhagic fever (DHF) and dengue shock syndrome (DSS). Severe dengue features plasma leakage (fluid escaping from blood vessels), leading to hemoconcentration, low blood pressure, organ impairment, and bleeding risk.
Dengue vs Severe Dengue: Why the Names Changed
Older terms—DHF and DSS—are now grouped under “severe dengue” in WHO guidance because not all severe cases bleed, and shock can occur without dramatic bleeding. The modern classification emphasizes:
- Dengue (without warning signs)
- Dengue with warning signs
- Severe dengue
- This helps clinicians identify risk earlier and act before shock develops.
How Capillary Leak Leads to Bleeding and Shock?
The heart of dengue haemorrhagic fever is “capillary leak.” Immune responses to the virus make vessels temporarily leaky, usually around days 3–7. Plasma moves out of circulation, concentrating red blood cells (hematocrit rises), dropping blood pressure, and narrowing pulse pressure. Platelets often fall, and along with fragile vessels, this can cause bleeding (gums, nose, heavy menstrual flow, or internal bleeding). The good news: this leak is transient; with timely fluids and monitoring, most people recover fully, and mortality can be kept below 1%.
- Unique insight: Think of severe dengue as a plumbing problem—not a bleeding problem first. The priority is restoring circulating volume safely, not chasing platelet numbers.
Consult a Top General Physician
How Dengue Spreads?
Aedes mosquitoes bite during the day, especially early morning and late afternoon. They thrive in urban settings and lay eggs in small collections of clean water (flower pot trays, buckets, bottle caps). When a mosquito bites an infected person and later bites someone else, the virus spreads. After an incubation of 4–10 days, illness begins [1,3].
The Aedes Mosquito: Daytime Biter, Urban Breeder
- Breeds in clean, stagnant water in and around homes.
- Rests indoors; prefers human blood.
- Bites through thin clothing; attracted to dark clothing and body heat.
Incubation and Infectious Periods
Symptoms typically start 4–10 days after a bite. People can transmit the virus to mosquitoes roughly from a day or two before symptoms to the first week of illness. Multiple dengue infections can occur over a lifetime; prior infection with one serotype may increase the risk of severe dengue in a subsequent infection by a different serotype.
Unique insight: Because Aedes rests indoors, indoor control (screens, eliminating water containers) can be more impactful than street spraying alone.
Symptoms and Phases of Dengue
Dengue fever often begins abruptly with high fever, intense headache, pain behind the eyes, muscle and joint pain (“breakbone fever”), nausea, vomiting, and a rash. Not everyone progresses to severe dengue—but it’s crucial to understand the phases.
Febrile Phase: High Fever and Body Aches
- Duration: 2–7 days
- Symptoms: high fever, severe headache, retro-orbital pain, myalgia, arthralgia, nausea/vomiting, mild bleeding (nose/gums)
- Labs: white cell count may drop; platelets may begin to fall
Critical Phase: Danger Around Defervescence
- Timing: Often 24–48 hours after fever subsides (defervescence), typically days 3–7
- What happens: plasma leakage, rising hematocrit (hemoconcentration), narrowing pulse pressure, possible fluid accumulation (pleural effusion, ascites), and shock in severe cases
- Warning signs: severe abdominal pain, persistent vomiting, mucosal bleeding, lethargy or restlessness, enlarged liver, sudden drop in platelets with rising hematocrit, fluid accumulation, postural dizziness, reduced urine output
- This is when dengue haemorrhagic complications emerge.
Recovery Phase: Rash, Fatigue, and Rebound
Timing: 2–4 days after the critical phase
- Signs: appetite returns, vital signs stabilize, urine output improves; a convalescent “white islands in a sea of red” rash may appear
- Fatigue can last weeks; mild itching or bradycardia may occur
Warning Signs That Need Urgent Care
Seek immediate care for persistent vomiting, intense abdominal pain, bleeding, black stools, cold clammy skin, confusion, or if passing very little urine. If symptoms persist or worsen, consult a doctor online with Apollo 24|7 for further evaluation.
- Data point: With timely recognition and proper fluid management, case fatality rates for severe dengue can be kept under 1%.
Diagnosis and When to Seek Care?
Diagnosis combines clinical assessment with laboratory tests. Early testing helps confirm dengue and guide monitoring intensity.
Tests (NS1, RT-PCR, IgM/IgG) and What They Mean?
- NS1 antigen: Detectable from day 1 to about day 7 of fever; a positive result early strongly supports dengue.
- RT-PCR: Detects viral RNA in the first week; can identify serotype.
- IgM/IgG serology: IgM appears around day 4–5; IgG indicates past infection or late phase rise.
- CBC: Platelet count (often falls below 100,000/μL in severe cases) and hematocrit (rising >20% suggests plasma leakage).
If you need testing, Apollo 24|7 offers convenient home collection for dengue tests such as NS1 antigen, dengue IgM/IgG, and CBC.
Key Blood Counts: Platelets and Hematocrit
- Platelets: Low platelets raise bleeding risk but are not the only factor; many people with low platelets don’t bleed.
- Hematocrit: A rising hematocrit with falling platelets is a red flag for plasma leakage—far more informative than watching platelets alone.
When to See a Doctor or Go to the Hospital?
- Immediate care: any warning signs, pregnancy, infants, older adults, significant comorbidities (kidney, heart, or liver disease), or if symptoms worsen around days 3–7.
- Hospitalization: suspected severe dengue (shock, severe bleeding, organ dysfunction), inability to maintain oral intake, or social reasons (living alone, poor access to care).
- If your fever persists beyond two days with worsening symptoms or warning signs, consult a doctor online with Apollo 24|7 or book a physical visit for further evaluation.
Unique insight: Keep a simple “illness day” log (Day 1 = first day of fever). Decisions are easier when everyone knows what “day” you’re on.
Home Care for Uncomplicated Dengue Fever
Most people can recover at home with supportive care, especially during the febrile phase, provided there are no warning signs.
Hydration Strategy and Safe Fever Control
- Oral fluids: Aim for frequent sips—ORS, coconut water, soups, diluted juices. Target pale yellow urine every 3–4 hours.
- Pain/fever: Use acetaminophen/paracetamol as directed. Avoid ibuprofen, aspirin, or other NSAIDs due to bleeding risk.
- Nutrition: Small, frequent meals; bland foods if nauseated.
What to Track Daily at Home?
- Temperature chart (morning/evening)
- Fluid intake and urine output (note any dark urine or long gaps)
- Bleeding (gums, nose, black stools), bruises, or new rash
- Abdominal pain, vomiting count, dizziness
- Day of illness (very important for anticipating the critical period)
Red Flags for Immediate Medical Attention
- Persistent vomiting (more than 3 times/day), severe abdominal pain, bleeding, fainting, cold extremities, drowsiness or agitation, very little urine
- If any red flag appears, go to the hospital urgently.
Unique insight: A simple kitchen-scale method—if advised by your clinician—can help check fluid balance at home: weigh yourself daily at the same time; unexpected rapid weight gain around days 3–5 (not due to drinking) may hint at fluid accumulating outside blood vessels.
Hospital Care for Dengue Haemorrhagic Fever
Severe dengue management focuses on careful fluid therapy and vigilant monitoring to reverse plasma leakage without causing fluid overload.
Fluid Resuscitation and Careful Monitoring
- Isotonic crystalloids (e.g., normal saline, Ringer’s lactate) are first-line.
- Boluses for shock; then adjust maintenance based on vital signs, urine output (goal ~1–1.5 mL/kg/hour), hematocrit trends, and signs of fluid overload.
- Colloids may be used in refractory shock in selected cases.
- Oxygen, close nursing, and frequent reassessment are essential.
Data point: With protocol-based fluids and monitoring, most patients stabilize within 24–48 hours as the critical phase passes.
When Platelets Are (and Aren’t) Transfused?
- Transfuse for significant bleeding or very low counts with bleeding risk; not for low platelet count alone.
- Routine prophylactic platelet transfusion is not recommended and may cause harm (volume overload, reactions).
What Your Doctors Watch Hour-by-Hour?
- Vital signs and pulse pressure
- Urine output and mental status
- Hematocrit and platelets trends; liver and kidney function
- Bedside ultrasound for pleural effusion/ascites if needed
Unique insight: A falling hematocrit after fluids is good—if accompanied by stable vitals and adequate urine. A falling hematocrit with unstable vitals can mean bleeding, demanding a different response.
Prevention: Personal, Home, and Community Actions
Stopping mosquito bites and eliminating breeding sites are your strongest defenses.
Repellents, Clothing, and Nets
Use EPA-registered repellents (DEET 20–30%, picaridin 20%, IR3535, or oil of lemon eucalyptus).
Wear light-colored, long sleeves/trousers; treat clothing with permethrin.
Use screens, fans, and bed nets (especially for daytime naps).
Eliminate Breeding Sites at Home
- Weekly: empty, scrub, or cover water containers (buckets, plant trays, rooftop tanks).
- Fix leaky taps; keep toilet lids closed.
- Dispose of tires, cans; store items under cover.
- Unique insight: “1-2-3 Rule” each week: 1 hour to inspect, 2 buckets emptied, 3 problem spots fixed.
Community Playbook During Outbreaks
- Neighborhood clean-up drives; larval source reduction
- Encourage school/work awareness, sick leave for febrile employees
- Report clusters to local health authorities for targeted control
- Consider novel approaches (e.g., Wolbachia mosquito programs) where available
Vaccines for Dengue
Two vaccines exist in select countries with specific eligibility rules: CYD-TDV (Dengvaxia) and TAK-003 (Qdenga). Policies vary by country and may change.
Who Is Eligible and Where?
- DengvaxiA. Recommended only for individuals with confirmed past dengue infection (seropositive) in certain age groups and regions; not for seronegative individuals due to increased risk of severe dengue after vaccination.
- Qdenga (TAK-003): Approved in several countries (e.g., EU, parts of Asia and Latin America); some nations recommend it broadly in endemic areas, others for defined age groups. Availability and guidance differ; discuss local recommendations with your clinician.
What to Ask Your Doctor Before Vaccination?
- Your dengue history or likelihood of past infection
- Local epidemiology and current recommendations
- Benefits vs risks by age and serostatus
Unique insight: Vaccines complement—not replace—vector control. Even vaccinated individuals should follow bite prevention.
Special Situations and Recovery
Some groups have a higher risk for severe outcomes; tailor vigilance and follow-up.
Children, Pregnancy, Older Adults, and Comorbidities
- Children: warning signs may be subtle; dehydration develops quickly.
- Pregnancy: risks include hemorrhage, preterm birth; coordinate obstetric and infectious disease care.
- Older adults/comorbidities (diabetes, hypertension, kidney disease): higher risk for complications; lower threshold for hospitalization.
If you’re pregnant or managing a chronic illness and develop a fever consistent with dengue, seek medical advice promptly; if your condition does not improve after initial care, book a physical visit to a doctor with Apollo 24|7.
Post-Dengue Fatigue and Return to Activity
- Expect fatigue for 2–4 weeks; pace your return to activity.
- Hydrate, balanced nutrition; gentle exercise as tolerated.
- Follow-up labs (CBC, liver enzymes) if advised; Apollo 24|7 offers home collection for tests such as CBC and LFTs if your clinician requests monitoring.
Myths vs Facts (papaya leaf, dirty water, antibiotics)
- Platelets: Low count alone rarely needs transfusion; clinical context matters.
- Papaya leaf: No strong evidence that it meaningfully raises platelets or changes outcomes.
- Dirty water myth: Aedes prefers clean, stagnant water.
- Antibiotics: Not effective against viruses; avoid unless a bacterial infection is proven.
Conclusion
Dengue haemorrhagic fever can be frightening, but knowledge and timely action save lives. Understand how dengue progresses through distinct phases and why the danger often peaks when the fever falls. Watch for warning signs—persistent vomiting, severe abdominal pain, bleeding, dizziness, little urine—and do not delay seeking care. At home, focus on steady hydration, safe fever control, and daily monitoring. In the hospital, protocol-driven fluids and close observation guide recovery and minimize complications. Prevention remains critical: protect against bites, eliminate breeding sites weekly, and stay informed about vaccine options where available. If your fever or symptoms aren’t improving, or if you’re pregnant, a child, older adult, or living with chronic illness, do not wait—consult a doctor online with Apollo 24|7 for further evaluation or book an in-person visit. Share this guide with family and neighbors; community awareness and action reduce risk for everyone.
Consult a Top General Physician
Consult a Top General Physician

Dr. Anand Ravi
General Physician
2 Years • MBBS, FEM
Bengaluru
PRESTIGE SHANTHINIKETAN - SOCIETY CLINIC, Bengaluru

Dr. Vivek D
General Physician
4 Years • MBBS
Bengaluru
PRESTIGE SHANTHINIKETAN - SOCIETY CLINIC, Bengaluru

Dr Syed Mateen Pasha
General Physician
2 Years • MBBS
Bengaluru
PRESTIGE SHANTHINIKETAN - SOCIETY CLINIC, Bengaluru

Dr. Syed Ismail Ali
General Practitioner
7 Years • MBBS
Hyderabad
Apollo 24|7 Clinic, Hyderabad

Dr. Ajay K Sinha
General Physician/ Internal Medicine Specialist
30 Years • MD, Internal Medicine
Delhi
Apollo Hospitals Indraprastha, Delhi
(225+ Patients)
Consult a Top General Physician

Dr. Anand Ravi
General Physician
2 Years • MBBS, FEM
Bengaluru
PRESTIGE SHANTHINIKETAN - SOCIETY CLINIC, Bengaluru

Dr. Vivek D
General Physician
4 Years • MBBS
Bengaluru
PRESTIGE SHANTHINIKETAN - SOCIETY CLINIC, Bengaluru

Dr Syed Mateen Pasha
General Physician
2 Years • MBBS
Bengaluru
PRESTIGE SHANTHINIKETAN - SOCIETY CLINIC, Bengaluru

Dr. Syed Ismail Ali
General Practitioner
7 Years • MBBS
Hyderabad
Apollo 24|7 Clinic, Hyderabad

Dr. Ajay K Sinha
General Physician/ Internal Medicine Specialist
30 Years • MD, Internal Medicine
Delhi
Apollo Hospitals Indraprastha, Delhi
(225+ Patients)
More articles from Dengue Fever Treatment
Frequently Asked Questions
How long does dengue fever last, and when is severe dengue most likely?
Fever usually lasts 2–7 days. The risk of severe dengue haemorrhagic complications is highest in the 24–48 hours after the fever begins to fall (defervescence), typically days 3–7.
Which painkiller is safe for dengue?
Use acetaminophen/paracetamol. Avoid ibuprofen, aspirin, and other NSAIDs due to bleeding risk (a key point in the management of dengue hemorrhagic fever).
What does the NS1 antigen test show?
NS1 detects dengue virus proteins early (days 1–7). A positive NS1 supports dengue diagnosis before IgM turns positive. Many labs (including Apollo 24|7) offer an NS1 antigen test home collection.
When should I worry about platelet count in dengue?
Platelet count often drops, but the trend with hematocrit and symptoms matters more than the number alone. Warning signs or a rising hematocrit with falling platelets suggest plasma leakage and the need for urgent care.
Can I get dengue again after recovering?
Yes. There are four dengue serotypes. Infection with one serotype does not protect against the others, and a subsequent infection can carry a higher risk of severe dengue.